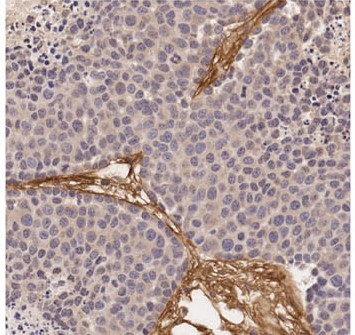
microscopic image of tissues

Advancing personalized medicine for breast cancer
While breast cancer can often be cured if caught early, once it spreads to other organs the five-year survival rate is just 28%. Dr. Luc Sabourin and his team hope to put the brakes on aggressive forms of breast cancer, and their latest study in Breast Cancer Research provides an important clue as to how to do this.
While breast cancer can often be cured if caught early, once it spreads to other organs the five-year survival rate is just 28%. Dr. Luc Sabourin and his team hope to put the brakes on aggressive forms of breast cancer, and their latest study in Breast Cancer Research provides an important clue as to how to do this.
The study focuses on periostin, a protein that plays a key role in remodeling the molecular scaffold that surrounds all our cells and keeps them in place. Breast cancer cells often express high levels of periostin (example in image) and this correlates with worse survival, but nobody knows exactly how periostin is controlled.
Dr. Sabourin and his team found that the level of periostin in breast cancer cells depends on several growth factors and regulatory pathways, including FGFR, TGF-beta, PI3K and AKT. Further research will be required to understand the relationship between these proteins and how they control periostin levels. However, it is an important step towards developing more personalized treatments for breast cancer.
Authors: Labrèche C, Cook DP, Abou-Hamad J, Pascoal J, Pryce BR, Al-Zahrani KN, Sabourin LA.
Funding: This study was funded by the Canadian Breast Cancer Foundation, the Canadian Institutes of Health Research, the Cancer Research Society and the Canadian Cancer Society Research Institute. All research at The Ottawa Hospital is also enabled by generous donations to The Ottawa Hospital Foundation.
The Ottawa Hospital is a leading academic health, research and learning hospital proudly affiliated with the University of Ottawa and supported by The Ottawa Hospital Foundation
Media contact
Jennifer Ganton
Director, Communications and Public Relations
Ottawa Hospital Research Institute
613-614-5253
jganton@ohri.ca
Learn more about:
The Ottawa Hospital is a leading academic health, research and learning hospital proudly affiliated with the University of Ottawa and supported by The Ottawa Hospital Foundation.


